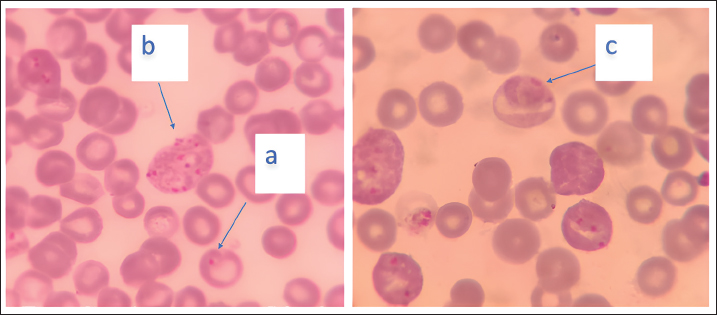

| Research Article | ||
Open Vet. J.. 2025; 15(4): 1599-1606 Open Veterinary Journal, (2025), Vol. 15(4): 1599-1606 Research Article Sacha inchi (Plukenetia volubilis) seed oil alleviates Plasmodium berghei infection in mice by reducing proinflammatory cytokine levels and inhibiting parasite growthRizky Setia Firdaus1, Nadiah Farah Fadilah1, Lucia Tri Suwanti2,3*, Heny Arwati4 and Heni Puspitasari31Postgraduate Student of Universitas Airlangga, Surabaya, Indonesia 2Division of Veterinary Parasitology, Faculty of Veterinary Medicine, Universitas Airlangga, Surabaya, Indonesia 3Toxoplasma Study Group, Institute of Trophical Disease, Universitas Airlangga, Surabaya, Indonesia 4Departement of Parasitology, Faculty of Medicine, Universitas Airlangga, Surabaya, Indonesia *Corresponding Author: Lucia Tri Suwanti. Division of Veterinary Parasitology, Faculty of Veterinary Medicine, Universitas Airlangga, Surabaya, Indonesia. Email: lucia-t-s [at] fkh.unaie.ac.id Submitted: 21/11/2024 Accepted: 15/03/2025 Published: 30/04/2025 © 2025 Open Veterinary Journal
AbstractBackground: Sacha inchi (Plukenetia volubilis) seed is a rich source of polyunsaturated fatty acids, namely omega-3 and omega-6, which provide various health benefits, especially in the prevention of inflammatory diseases. Malaria, caused by Plasmodium species, triggers inflammasome activation, leading to the release of proinflammatory cytokines. Aim: This study aimed to reveal the immunomodulatory potential effect of Sacha inchi seed oil (SISO) on parasite growth and proinflammatory cytokine expression (Interleukin-6, Il-8, and Il-12) in Plasmodium berghei-infected mice. Methods: Twenty-five BALB/c mice were divided into five groups, including the control group (G1), infected and untreated group (G2), and three infected groups treated with SISO at doses of 250 mg/kg body weight (G3), 500 mg/kg body weight (G4), and 1,000 mg/kg body weight (G5). Parasitemia levels were determined by calculating the percentage of infected red blood cells, whereas cytokine levels were measured using ELISA. Results: SISO treatment significantly reduced parasite growth in the 500 mg/kg body weight (18.12%) and 1,000 mg/kg body weight (17.12%) groups compared with the untreated group (30.18%). Levels of Il-8 and Il-12 showed significant differences (p < 0.05), with the highest levels recorded in the untreated group (G2), followed by the 250 mg/kg body weight therapy group (G3). The mice in the groups treated with 500 mg/kg body weight (G4) and 1,000 mg/kg body weight (G5) showed a decrease, and the value was even close to the control group (G1). However, no significant changes in Il-6 levels were observed across the groups. Conclusion: Sacha inchi seed oil has the potential to modulate the immune response of P. berghei-infected mice through the inhibition of parasite growth and reduction of the proinflammatory cytokine levels Il-12 and Il-8, depending on the dose. A dose of 500 mg/kg body weight effectively reduced parasite growth and the levels of observed proinflammatory cytokines. Keywords: Immunomodulatory, Malaria, Parasite growth, Proinflammatory cytokines, Sacha inchi seed oil. IntroductionPlasmodium berghei is a protozoan parasite responsible for rodent malaria. It is the most widely used parasite for malaria research (Lakkavaram et al., 2020). This parasite shares several key similarities with human malaria, including its structure, physiology, and life cycle, making it suitable for in vivo studies (Sawant et al., 2023). Additionally, P. berghei is easily maintained in laboratory mice, further facilitating its use in experimental studies (Lin et al., 2023). Malaria remains a significant global public health concern, with nearly half of the world’s population at risk of infection. The primary Plasmodium species responsible for human malaria are Plasmodium falciparum, Plasmodium vivax, Plasmodium ovale, Plasmodium malariae, and Plasmodium knowlesi. According to the World Health Organization in the World Malaria Report 2022, the number of malaria cases in Indonesia is the second largest in Southeast Asia after India. On a global scale, malaria cases rose to 247 million in 2021, up from 245 million in 2020, with the majority of cases reported in Africa. Furthermore, malaria-related deaths increased during the COVID-19 pandemic by approximately 63,000 cases due to the disruption of prevention and control strategies (WHO, 2022). Innate and adaptive immunity participate in the immune response to malaria infection. During early infection, the innate immune system recognizes the presence of Plasmodium through pattern recognition receptors (PRRs) on immune cells. This recognition triggers an inflammatory response, leading to the mobilization of immune cells, such as monocytes, macrophages, and neutrophils, to the infection site (Rochford and Kazura, 2020). Innate immune cells play an important role in controlling infections by phagocytosing parasites and releasing proinflammatory cytokines. The adaptive immune response is activated as the infection progresses. As antigen-presenting cells, dendritic cells and macrophages engulf and process parasite antigens, presenting them to CD4+ T cells (Burrack et al., 2019). Once activated, CD4+ T cells release cytokines to activate cytotoxic CD8+ Ts or B lymphocytes. CD8+ T cells can directly lyse infected cells, such as infected red blood cells. Meanwhile, B cells are responsible for producing anti-plasmodium parasite antibodies by neutralizing the parasite, inhibiting its invasion into red blood cells, and encouraging other immune cells to lyse the parasite (Rochford and Kazura, 2020). The host immune response to malaria, both innate and adaptive, has implications for inflammatory reactions. According to Berg et al. (2014), P. falciparum infection frequently triggers inflammatory pathways, leading to both localized and systemic inflammatory responses involving the release of various cytokines. The inflammatory response in malaria sufferers is characterized by the expression of pro-inflammatory cytokines such as Il-6, Il-8, IFN-γ, and TNF-α, which are cytokines intended to control parasite growth and eliminate it (Popa and Popa 2021). However, excessive inflammatory reactions can be detrimental to patients because they contribute to organ damage and severe systemic inflammation, which may increase morbidity and lead to mortality in patients with malaria (Berg et al., 2014). The inflammatory response in malaria needs to be controlled with natural ingredients. Several researchers have shown that natural ingredients can reduce inflammation. One of the natural ingredients to modulate the response to parasitic infections is polyunsaturated fatty acids (PUFAs), namely omega-PUFA/ω-PUFA/n-PUFA (Alhusseiny and El-Beshbishi, 2020; Cãrdenas et al., 2021), because PUFA is known to be gene modulators for regulating inflammation (Balić et al., 2020). In vitro studies have revealed that n-3 PUFAs decrease the level of proinflammatory cytokines for example IL-6 in microglial cells (Joffre et al., 2019). Another study reported that n-3 PUFA decrease circulating IL-6 levels in patients with cancer (Guo et al., 2023). One of the natural ingredients rich in omega PUFAs is the seed of the Sacha inchi plant (Plukenetia volubilis). Sacha inchi is an indigenous plant from the Amazon forest. It has recently spread to various countries and has been successfully cultivated in Indonesia (Supriyanto et al., 2022). Sacha inchi seed oil (SISO) contains mostly PUFA (Wang et al., 2018), especially linolenic and linoleic acids (Lu et al., 2023). The use of SISO in malaria infections has never been performed. This paper reports the immunomodulatory effects of SISO in mice infected by P. berghei ANKA based on parasite growth and proinflammatory cytokine (Interleukin-6, IL-8, and IL-12) levels. Materials and MethodsSacha inchi seed oil is a finished product obtained from the market. Plasmodium berghei strain ANKA was obtained from the Parasitology Laboratory of the Faculty of Medicine, Brawijaya University, Malang. In this study, 30 BALB/c mice were used, with details of 5 as donor mice and 25 as experimental mice. Parasite propagation in donor miceFive donor mice were infected intraperitoneally with 200 μl of P. berghei ANKA-infected blood. Parasitemia was observed every day, and once it reached approximately 20%, blood from donor mice was collected, and used to infect the experimental mice. Infection and treatment of experimental miceTwenty-five experimental mice were divided into noninfected and infected groups. Five mice were grouped as a control group (without infection or therapy) (G1). Twenty mice were intraperitoneally infected by 1 × 106 erythrocytes from donor mice. Twenty infected mice were divided into 4 groups: including 5 mice grouped as infected and untreated (G2); 5 mice infected and treated with SISO at a dose of 250 mg/kg body weight (G3); 5 mice infected and medicated with 500 mg/kg body weight SISO (G4) and 5 mice infected and treated with 1,000 mg/kg body weight SISO (G5). Therapy was performed 1 day after infection with a therapeutic dose according to the study guidelines by Herrera-Calderãn et al. (2019), and SISO was administered orally for 4 days. Parasitemia observation and parasite growth calculationParasitemia was observed on day 1 (before SISO therapy) and on day 5 postinfection in the infected mice groups (G2–G5) to calculate parasite growth. Parasitemia is the percentage of red blood cells infected with parasites in a given sample. The percentage of parasitemia was calculated by counting the number of malaria-infected erythrocytes in a sample of 1,000 erythrocytes using the following formula:
Parasite growth was calculated using the following formula: Parasite growth=%Parasitemia on day 5 - % Parasitemia on day 1. Proinflammatory cytokinesOn the fifth day after infection, all mice were sacrificed, and blood was collected from all mice in all groups to examine the levels of inflammatory cytokines, namely Il-6, Il-8, and Il-12, in serum using the ELISA technique. Cytokine levels are expressed as optical density (OD) values. Data analysisThe parasite growth and OD values of interleukins data were analyzed statistically using one way analysis of variance with the SPSS program. Ethical ApprovalThe Ethics Commission Institution, Animal Care and Use Committee (ACUC), Faculty of Veterinary Medicine, Universitas Airlangga, has approved the use of experimental animals in this study by issuing an ethics certificate No: 2.KEH.183.12.2023 on December 20, 2023. ResultsParasite growthThe results of calculating the growth of Plasmodium parasites in the erythrocytes of mice treated with SISO are presented in Table 1. Parasite growth calculations were performed only in the infected mice groups (G2–G5), and a picture of erythrocytes infected with Plasmodium is shown in Figure 1. The highest growth of the parasite in the mouse group infected without SISO therapy (G2), whereas the growth of parasites in the treated group was lower and statistically significant difference (p < 0.05). Furthermore, Duncan’s post hoc test showed that mice in groups G4 and G5 (mice treated with a dose of 500 mg/kg body weight and 1,000 mg/kg body weight) were significantly different from the infection group without therapy (G2). The group of mice treated with a dose of 250 mg/kg body weight (G3) experienced a decrease in parasite growth, but not significantly compared with the untreated group (p > 0.05). These results indicate that SISO can reduce Plasmodium growth, depending on the dose. Table 1. Mean and standard deviation of parasite growth in mice infected with P. berghei.
Fig. 1. Erythrocytes of mice infected with P. berghei (1,000x magnification). a. ring stage, b. schizont stage, and c. gametocyte stage of P. berghei in erythrocytes. Table 2. Mean and standard deviation of serum proinflammatory cytokine levels in mice infected with P. berghei.
Proinflammatory cytokinesThe mean and standard deviation of serum proinflammatory cytokine levels in mice infected with P. berghei are presented in Table 2. The OD values of Il-6 in all groups were not significantly different (p > 0.05), whereas the OD values of Il-12 and Il-8 differed between the infected and uninfected groups (p < 0.05). The highest OD values of Il-12 and Il-8 were observed in the infected and untreated groups (G2). The OD values of Il-8 and Il-12 serum in the mice group decreased compared with the untreated infected group. Both Il-8 and Il-12 in the G4 and G5 therapy groups had significant differences in OD values compared to G2 the (untreated group) (p < 0.05), although the OD values of Il-8 and Il-12 in the 250 mg/kg body weight(G3) therapy group were lower but not statistically significantly different compared to the untreated group (G2) (p > 0.05). These findings indicate that SISO decreased the Il-8 and Il-12 levels, even the decrease in the group treated with 500 mg/kg body weight (G4) was not statistically different from the uninfected group (p > 0.05). DiscussionMalaria in rodents caused by P. berghei is often used as a model for studying pathogenesis, parasite growth, and drug effectiveness. The present study aimed to describe the effects of SISO on the growth of parasites and levels of proinflammatory cytokines. The growth of Plasmodium in mice treated with a dose of 500 mg/kg body weight (G4) and 1,000 mg/kg body weight (G5) were significantly decreased compared with the infection group without therapy (G2). These results demonstrated that SISO can obstruct parasite growth depending on the dose. Parasite growth in mice treated with a dose of 250 mg/kg body weight (G3) decreased, but not significantly, compared with the untreated group (p > 0.05). The reduction in Plasmodium growth may be attributed to the high PUFA content in SISO, because PUFAs are toxic to parasites (Guillaume et al., 2015). PUFAs are categorized into two main groups, such as omega-3 and omega-6, with linolenic acid being an omega-3 PUFA and linoleic acid classified as an omega-6 PUFA (Rahman et al., 2024). Sacha inchi seed oil is a major PUFA (Wang et al., 2018), especially linolenic acid and linoleic acid, with estimated contents of 44.30%–51.62% and 34.08%–36.13%, respectively (Lu et al., 2023). According to Rahman et al., (2024), both omega-3 and omega-6 PUFAs reduce parasite growth and survival by producing lipoxins, resolvins, and protectins, offering protection against various protozoan infections in both in vivo and in vitro settings. These omega-PUFAs regulate the host immune response through mechanisms such as inhibiting the arachidonic acid metabolic pathway, generating anti-inflammatory molecules, altering lipids in cells, and activating receptors in the nucleus. This study is in line with Melariri et al. (2012), who reported the strong inhibition of parasitemia in P. berghei infections in mice treated with linolenic and linoleic acids with a purity of 99%. Sawant et al. (2023) reported that Annomaal seed oil, which is high in fatty acids and contains 38.86% linoleic acid, may play a significant role in inhibiting parasite activity. Ommi et al. (2022) reported that C18 fatty acids, oleic acid, and linoleic acid can actively fight the growth of Plasmodium. PUFAs are susceptible to oxidation by forming superoxide radicals, which can inhibit pathogen growth and cause parasite death (Silva et al., 2020; Ommi et al., 2022). Another study demonstrated that the administration of omega-3 fish oil rich in DHA controls parasites during the critical period of malaria infection, thereby increasing survival rates in experimental mice infected with P. berghei (Carpinter et al., 2024). The mechanism of parasitemia inhibition depends on the concentration, unsaturation, and chain length of fatty acids (Rahman et al., 2024). This is a possible explanation for why the inhibition of parasite growth in mice treated with a dose of 250 mg/kg body weight was not significantly different from the uninfected group. SISO 500 mg/kg body weight and 1,000 mg/kg body weight have been significantly able to inhibit parasite growth, but it still cannot eliminate all parasites. It is possible that the PUFAs in SISO in this study are not pure, so purification is necessary for their use as antimalarial agents. Another consideration is that the therapy duration was only 4 days. Hence, further study with an extended treatment period is needed. In addition to PUFA content, SISO also functions as an antioxidant due to its phenol, tocopherol, and carotenoid content (Mdh Rodzi and Lee, 2022). Maya et al. (2023) reported that Indonesian SISO has very strong antioxidant activity, as indicated by an IC50 value of 8,859 ppm in the results of their research. The antioxidant, anti-inflammatory, and immunomodulatory properties of Sacha inchi have been reported by several researchers (Nascimento et al., 2013; Chirinos et al., 2016; Wuttisin et al., 2020). In Plasmodium infection, oxidative stress occurs (Gomes et al, 2022), and the antioxidant activity of SISO may also play a role in reducing parasite growth. In recent years, proinflammatory cytokines have gained significant attention due to their involvement in the pathogenesis of various diseases, including malaria, where they are linked to the severity of the disease (Obeng-Aboagye et al., 2023). Pro-inflammatory cytokines promote inflammation and tissue damage (Kim and Moudgil, 2017). In this study, the levels of Il-6 in all groups were not significantly different (p > 0.05), whereas the levels of Il-12 and Il-8 were lower in infected and treated mice compared to mice infected but not treated (p < 0.05). According to Popo and Popa, (2021), interleukin-6 and interleukin-8 are proinflammatory cytokines that may be linked to the pathogenesis of malaria. Interleukin (Il)-6 is an essential cytokine in the innate immune response (Rose-John, 2018). However, in this study, Il-6 is not significantly different between all groups. The contribution of Il-6 to malaria infection still has a dualism of opinion. Wilairatana et al. (2022) stated that Il-6 is a marker for severe malaria, based on the observation that levels of Il-6 increased substantially in patients with severe malaria compared with those non severe malaria. A different opinion was expressed by Hamilton et al. (2023), who found that Il-6 was not involved in severe malaria cases because their analysis did not identify the role of Il-6 in the development of severe malaria. These results suggest that infection in mice in this study did not cause severe malaria. The highest OD values of Il-12 and Il-8 were observed in the infected and untreated groups (G2). These findings were consistent with the study carried out by Obeng-Aboagye et al. (2023), which showed that levels of pro-inflammatory cytokines circulating, such as Il-12 and Il-8, dramatically increased in severe malaria compared with the control group, demonstrating that P. berghei infection causes an inflammatory response. Malaria is an extremely inflammatory disease associated with oxidative stress, in which the production of reactive oxygen species (ROS) is an important signaling molecule in host responses to Plasmodium infection (Vasquez et al., 2021). At the stage of Plasmodium-infecting erythrocytes, the link between inflammation and oxidative stress was demonstrated by the activation of macrophages and dendritic cells (Gotz et al., 2019; Ty et al., 2019) through ROS, leading to the release of inflammatory cytokines. These results are similar to those of Berg et al. (2014), who reported that P. falciparum infection is often associated with both systemic and local inflammatory reactions involving the production of various cytokines. In Plasmodium infection, the innate immune response is the primary defense mechanism, followed by adaptive immunity, which involves the activity of T and B cells and antibody production (Lãpez et al., 2017). During blood infection (parasitemia), merozoites are released and invade new red blood cells. At this stage, host immune cells produce several proinflammatory cytokines such as Il-1β, Il-6, Il-8, Il-12, IFN-γ, and tumor necrosis factor (TNF), as host defense against the presence of the parasite to eliminate and inhibit parasite growth (Popo and Popa, 2021). The increase in Il-12 levels in the study is also in accordance with Sarangi et al. (2014) statement that serum Il-12 levels increased in all patients with malaria, with increasing Il-12 levels being a predictor of acute malaria infection. Infected red blood cells express parasite antigens as pathogen-associated molecular patterns (PAMPs) and bind to PRRs located on the membrane of innate immune cells, such as dendritic cells and macrophages (Kalia et al., 2021; Ramachandran and Sharma, 2022). Malaria PAMPs that interact with TLRs on PRRs trigger the production of cytokines such as Il-12 (Dunst et al., 2017). Interleukin-12 activates naive Th cells to differentiate into Th1 cells that produce TNF-α, which TNF-α will activate neutrophils to produce Il-8 (Kotepui et al., 2023). Interleukin-8 (Il-8) contributes to the progression of malaria infection, especially by inducing neutrophils at the onset of the inflammation process (Kotepui et al., 2023). The OD values of Il-8 and Il-12 serum in the mice were decreased compared with those in the untreated infected group. Both Il-8 and Il-12 in the G4 and G5 therapy groups had significant differences in OD values compared to G2 the (untreated group) (p < 0.05), although the OD values of Il-8 and Ii-12 in the 250 mg/kg body weight (G3) therapy group were lower but not statistically significantly different compared to the untreated group (G2) (p > 0.05). These findings indicate that SISO decreased the IL-8 and IL-12 levels, even though the decrease in the group treated with 500 mg/kg body weight (G4) was not statistically significant compared with the uninfected group (p > 0.05). Decreases in Il-8 and Il-12 levels are possible due to the PUFA content in SISO. Seeds of Sacha inchi plant are rich in PUFAs, namely omega-3 and omega-6 fatty acids (Wang et al., 2018; Kodahl, 2020). PUFAs in Sacha inchi consist of omega-3 and omega-6, which are known to inhibit inflammatory reactions by regulating cytokine production (Supriyanto et al., 2022). The anti-inflammatory effects of omega-3 PUFAs are extensive, with studies showing that they lower levels of pro-inflammatory cytokines, including Il-8 (Kang and Weylandt, 2008). According to a review by Khorsan et al. (2014), both experimental animal studies and clinical studies have shown that omega-3 fatty acids have a beneficial influence on managing autoimmune and inflammatory diseases, including inflammatory bowel disease, rheumatoid arthritis, Crohn’s disease, and other related disorders. One way PUFAs regulate gene expression involves activating transcriptional regulators through peroxisome proliferator-activated receptors (PPARs). The binding of PPARs to their coactivator reduces the number of coactivators available to bind proinflammatory transcription factors, such as nuclear factor kappa B (NF-κB), resulting in the transcriptional downregulation of various proinflammatory genes, such as TNF and interleukins (Balić et al., 2020). The results of this study strengthen the investigation carried out by Angriani et al. (2017), which reported that omega-3 PUFAs had anti-inflammatory effects and downregulated the expression of Il-8 by suppressing NF-kB. The anti-inflammatory effect of PUFAs in reducing Il-8 was also demonstrated by Erdinest (2012) in an in vitro study involving human corneal epithelial cells. The administration of omega-3 PUFAs reduced the infiltration of immune cells such as neutrophils, macrophages, T cells, and NK cells in mice and patients with IBD and has been shown to reduce proinflammatory cytokines such as Il-12 (Tu et al., 2020). Similarly, in patients with lupus, the administration of omega-3 significantly reduced several inflammatory markers, including circulating Il-12 (Li et al., 2019). The review by Balić et al. (2020) reported that PUFA inhibits interferon-gamma (IFN-γ) production and Il-12 secretion by dendritic cells. ConclusionIn conclusion, Sacha inchi seed oil modulated the immune response of P. berghei-infected mice through the inhibition of parasite growth and reduction of the pro-inflammatory cytokine levels Il-12 and Il-8, depending on the dose. A dose of 500 mg/kg body weight effectively reduced parasite growth and the levels of observed proinflammatory cytokines. To use Sacha inchi seed oil as an anti-malarial agent, it is essential to purify the active compounds present to ensure complete parasite elimination. AcknowledgmentsGratitude is extended to the Airlangga Research Fund for providing a Superior Basic Research Grant 1507/UN3.FKH/PT.01.03/2024. The authors are also grateful to the Parasitology Laboratory, Faculty of Medicine, Brawijaya University, Malang, for providing Plasmodium berghei strain ANKA. Conflicts of interestThe authors declare that they have no conflicts of interest. Authors’ contributionsRSF and NFR: literature review, data collection, care, and management of laboratory animals. LTS: creation and submission of a proposal, lead, and integration of all phases of research, and writing and submission of an article. HA: Plasmodium isolates, infecting experimental mice, parasite counting, and proofreading article. HP: blood smear staining, Elisa, and data analysis. ReferencesAngriani, N., Suradi and Sutanto. Y.S. 2017. Effects of omega-3 polyunsaturated fatty acids to the serum level of Interleukin-8, percentage of forced expiratory volume in 1 second (%FEV1), and COPD assesment test scores in stable COPD patients. J. Respir. Indo. 37(4), 265–277. Alhusseiny, S.M., El-Beshbishi, S.N. 2020. Omega polyunsaturated fatty acids and parasitic infections: An overview. Acta Trop. 207, 105466. doi: 10.1016/j.actatropica.2020.105466 Balić, A., Vlašić, D., Žužul, K., Marinović, B. and Bukvić Mokos, Z. 2020. Omega-3 versus omega-6 polyunsaturated fatty acids in the prevention and treatment of inflammatory skin diseases. Int. J. Mol. Sci. 21(3), 741. doi: 10.3390/ijms21030741 Berg, A., Patel, S., Gonca, M., David, C., Otterdal, K., Ueland, T., Dalen, I., Kvalãy, J.T., Mollnes, T.E., Aukrust, P. and Langeland, N. 2014. Cytokine network in adults with falciparum Malaria and HIV-1: increased IL-8 and IP-10 levels are associated with disease severity. PLoS One. 9(12), e114480; doi: 10.1371/journal.pone.0114480 Burrack, K.S., Hart, G.T. and Hamilton, S.E. 2019. Contributions of natural killer cells to the immune response against Plasmodium. Malar. J. 18(1), 321–329; doi: 10.1186/s12936-019-2953-1 Cãrdenas, D.M., Gãmez Rave, L.J. and Soto, J.A. 2021. Biological activity of Sacha inchi (Plukenetia volubilis Linneo) and potential uses in human health: a review. Food Technol. Biotechnol. 59(3), 253–266; doi: 10.17113/ftb.59.03.21.6683 Carpinter B.A., Renhe D.C., Bellei J.C.B., Vieira C.D., Rodolphi C.M., Ferreira M.V.R., de Freitas C.S., Neto A.F.D.S., Coelho E.A.F., Mietto B.D.S., Gomes F.L.R., Rocha V.N. and dan Scopel K.K.G. 2024. DHA-rich fish oil plays a protective role against experimental cerebral malaria by controlling inflammatory and mechanical events from infection. J. Nut. Biochem. 123, 109492; doi: 10.1016/j.jnutbio.2023.109492 Chirinos, R., Necochea, O., Pedreschi, R., and Campos, D. 2016. Sacha inchi (Plukenetia volubilis L.) shell: an alternative source of phenolic compounds and antioxidants. Int. J. Food Sci. Technol. 51, 986–993; doi: 10.1111/ijfs.13049 Dunst, J., Kamena, F. and Matuschewski, K. 2017. Cytokines and chemokines in cerebral Malaria pathogenesis. Front. Cell. Infect. Microbiol. 7, 324; doi: 10.3389/fcimb.2017.00324 Erdinest, N., Shmueli, O., Grossman, Y., Ovadia, H. and Solomon, A. 2012. Anti-inflammatory effects of alpha linolenic acid on human corneal epithelial cells. Invest. Ophthalmol. Vis. Sci. 53(8), 4396–4406; doi: 10.1167/iovs.12-9724 Gomes, A.R.Q., Cunha, N., Varela, E.L.P., Brígido, H.P.C., Vale, V.V., Dolabela, M.F., De Carvalho, E.P. and Percãrio, S. 2022. Oxidative stress in Malaria: potential benefits of antioxidant therapy. Int. J. Mol. Sci. 23(11), 5949; doi: 10.3390/ijms23115949 Gotz, A., Ty, M.C. and Rodriguez, A. 2019. Oxidative stress enhances dendritic cell responses to Plasmodium Falciparum. Immunohorizons 3(11), 511–518; doi: 10.4049/immunohorizons.1900076 Guillaume, C., Payré, C., Jemel, I., Jeammet, L., Bezzine, S., Naika, G.S., Bollinger, J., Grellier, P., Gelb, M.H., Schrével, J., Lambeau, G. and Deregnaucourt, C. 2015. In vitro anti-Plasmodium falciparum properties of the full set of human secreted phospholipases A2. Infect. Immun. 83, 2453–2465. doi: 10.1128/IAI.02474-14 Guo, Y., Ma, B., Li, X., Hui, H., Zhou, Y., Li, N. and Xie, X.2023. n-3 PUFA can reduce IL-6 and TNF levels in patients with cancer. Br. J. Nutr. 129(1), 54–65; doi: 10.1017/S0007114522000575. Hamilton, F., Mitchell, R.E., Constantinescu, A., Hughes, D., Cunnington, A., Ghazal, P. and Timpson, N.J. 2023. The effect of interleukin-6 signaling on severe malaria: a Mendelian randomization analysis. Int. J. Infect. Dis. 129, 251–259; doi: 10.1016/j.ijid.2023.02.008 Herrera-Calderon, O., Yuli-Posadas, R.A., Tinco-Jayo, J.A., Enciso-Roca, E., Franco-Quino, C., Chumpitaz-Cerrate, V. and Figueroa-Salvador, L. 2019. Neuroprotective effect of sacha inchi oil (Plukenetia volubilis L.) in an experimental model of epilepsy. Pharmacogn. J. 11(6), 1591 -1596. doi: 10.5530/pj.2019.11.243 Joffre, C., Rey, C. and Layé, S. 2019. N-3 Polyunsaturated fatty acids and the resolution of neuroinflammation. Front. Pharmacol. 10, 1022; doi: 10.3389/fphar.2019.01022 Kalia, I., Anand, R., Quadiri, A., Bhattacharya, S., Sahoo, B. and Singh, A.P. 2021. Plasmodium berghei-Released Factor, PbTIP, modulates the host innate immune responses. Front. Immunol. 12, 699887; doi: 10.3389/fimmu.2021.699887 Kang, J.X. and Weylandt, K.H. 2008. Modulation of inflammatory cytokines by omega-3 fatty acids. Subcell. Biochem. 49, 133–143; doi: 10.1007/978-1-4020-8831-5_5 Khorsan, R., Crawford, C., Ives, J.A., Walter, A.R. and Jonas, W.B. The 2014. Effect of Omega-3 fatty acids on biomarkers of inflammation: a rapid evidence assessment of the literature. Mil. Med. 179 (Issue suppl_11), 2–60; doi: 10.7205/MILMED-D-14-00339 Kim, E.Y. and Moudgil, K.D. 2017. Immunomodulation of autoimmune arthritis by pro-inflammatory cytokines. Cytokine 98, 87–96; doi: 10.1016/j.cyto.2017.04.012 Kotepui, M., Mala, W., Kwankaew, P., Mahittikorn, A., Masangkay, F.R. and Kotepui, K.U. 2023. A systematic review and meta-analysis of changes in interleukin-8 levels in malaria infection. Cytokine 169, 156262; doi: 10.1016/j.cyto.2023.156262 Kodahl, N. 2020. Sacha inchi (Plukenetia volubilis L.) from lost crop of the Incas to part of the solution to global challenges? Planta 251(4), 80; doi: 10.1007/s00425-020-03377-3 Lakkavaram, A., Lundie, R.J., Do, H., Ward, A.C. and de Koning-Ward, T.F. 2020. Acute Plasmodium berghei Mouse infection elicits perturbed erythropoiesis with features that overlap with anemia of chronic disease. Front. Microbiol. 11, 702; doi: 10.3389/fmicb.2020.00702’ Li, X., Bi, X., Wang, S., Zhang, Z., Li, F. and Zhao, A.Z. 2019. Therapeutic potential of ω-3 polyunsaturated fatty acids in human autoimmune diseases. Front. Immunol. 10, 2241; doi: 10.3389/fimmu.2019.02241 Lin, J., Zeng, S., Chen, Q., Liu, G., Pan, S. and Liu, X. 2023. Identification of disease-related genes in Plasmodium berghei by network module analysis. BMC. Microbiol. 23(2023), 264; doi: 10.1186/s12866-023-03019-0 Lãpez, C., Yepes-Pérez, Y., Hincapié-Escobar, N., Díaz-Arévalo, D. and Patarroyo, M.A. 2017. What is Known about the immune response induced by Plasmodium vivax malaria vaccine candidates? Front. Immunol. 8, 126; doi: 10.3389/fimmu.2017.00126 Lu, W.C., Chiu, C.S., Chan, Y.J., Mulio, A. T. and Li, P.H. 2023. New perspectives on different Sacha inchi seed oil extractions and its applications in the food and cosmetic industries. Crit. Rev. Food Sci. Nut. 65, 475–493; doi: 10.1080/10408398.2023.2276882 Maya, I., Winardi, D.O., Amalia, E., Mita, S.R., Kusumawulan, C.K., Putriana, N.A. and. Sriwidodo, S. 2023. Physicochemical characteristics, fatty acid profile, and in vitro antioxidant activity evaluation of Sacha inchi seed oil from Indonesia. Cosmetics 10, 171; doi: 10.3390/cosmetics10060171 Melariri, P., Campbell, W., Etusim, P. and Smith, P. 2012. In vitro and in vivo antimalarial activity of linolenic and linoleic acids. Adv Stud Biol. 4(7), 333–349. Mhd Rodzi, N.A.R. and Lee, L.K. 2022. Sacha inchi (Plukenetia Volubilis L.): recent insight on phytochemistry, pharmacology, organoleptic, safety and toxicity perspectives. Heliyon 8(9), e10572; doi: 10.1016/j.heliyon.2022.e10572 Nascimento, A.K.L., Melo-Silveira, R.F., Dantas-Santos, N., Fernandes, J.M., Zucolotto, S.M., Rocha, H.A.O. and Scortecci, K.C. 2013. Antioxidant and antiproliferative activities of leaf extracts from Plukenetia volubilis Linneo (Euphorbiaceae). Evid. Based Complement. Alternat. Med. 2013, 1–10; doi: 10.1155/2013/950272 Obeng-Aboagye, E., Frimpong, A., Amponsah, J.A., Danso, S.E., Owusu, E.D.A. and Ofori, M.F. 2023. Inflammatory cytokines as potential biomarkers for early diagnosis of severe malaria in children in Ghana. Malar J. 22(1), 220; doi: 10.1186/s12936-023-04652-w Ommi, N.B., Abdullah, M., Guruprasad, L and Babu, P.P. 2022. Docosahexaenoic acid is potent against the growth of mature stages of Plasmodium falciparum; inhibition of hematin polymerization a possible target. Parasitol. Int. 89, 102581. doi: 10.1016/j.parint.2022.102581 Popa, G.L. and Popa, M.I. 2021. Recent advances in understanding the inflammatory response in malaria: a review of the dual role of cytokines. J. Immunol. Res. 2021, 7785180; doi: 10.1155/2021/7785180 Rahman, S.U., Weng, T.N., Qadeer, A., Nawaz, S., Ullah, H. and Chen C.C. 2024. Omega-3 and Omega-6 polyunsaturated fatty acids and their potential therapeutic role in protozoan infections. Front. Immunol. 15, 1339470; doi: 10.3389/fimmu.2024.1339470 Ramachandran, A. and Sharma, A. 2022. Dissecting the mechanisms of pathogenesis in cerebral malaria. PLoS Pathog. 18(11), e1010919; doi: 10.1371/journal.ppat.1010919 Rochford, R. and Kazura, J. 2020. Introduction: Immunity to Malari. Immunol. Rev. 293, 5–7; doi: 10.1111/imr.12831 Rose-John, S. 2018. Interleukin-6 family cytokines. Cold Spring Harb. Perspect. Biol. 10(2), a028415; doi: 10.1101/cshperspect.a028415 Sarangi, A., Mohapatra, P.C., Dalai, R.K. and Sarangi, A.K. 2014. Serum IL-4, IL-12 and TNF-alpha in malaria: a comparative study associating cytokine responses with severity of disease from the Coastal Districts of Odisha. J. Parasit. Dis. 38, 143–147; doi: 10.1007/s12639-013-0237-1. Sawant, S.S., Gabhe, S.Y. and Singh, K.K. 2023. In vitro effect on Plasmodium falciparum and in vivo effect on Plasmodium berghei of annomaal, an oily fraction obtained from the seeds of Annona squamosa. Molecules 28, 5472; doi: 10.3390/molecules28145472 Silva, A.R., Moraes, B.P.T. and Gonãalves-de-Albuquerque, C.F. 2020. Mediterranean diet: lipids, inflammation, and malaria infection. Int. J. Mol. Sci. 21, 4489; doi: 10.3390/ijms21124489 Supriyanto, S., Imran, Z., Ardiansyah, R., Auliyai, B., Pratama, A. and Kadha, F. 2022. The effect of cultivation conditions on Sacha inchi (Plukenetia volubilis L.) seed production and oil quality (Omega 3, 6, 9). Agronomy 12(3), 636; doi: 10.3390/agronomy12030636 Tu, M., Wang, W., Zhang, G. and Hammock, B.D. 2020. ω-3 Polyunsaturated fatty acids on colonic inflammation and colon cancer: roles of lipid-metabolizing enzymes involved. Nutrients 12(11), 3301; doi: 10.3390/nu12113301 Ty, M.C., Zuniga, M., Gotz, A., Kayal, S., Sahu, P.K., Mohanty, A., Mohanty, S., Wassmer, S.C. and Rodriguez, A. 2019. Malaria inflammation by xanthine oxidase-produced reactive oxygen species. EMBO Mol. Med. 11 (8), e9903; doi: 10.15252/emmm.201809903 Vasquez, M., Zuniga, M. and Rodriguez, A. 2021. Oxidative stress and pathogenesis in Malaria. Front. Cell. Infect. Microbiol. 11, 768182; doi: 10.3389/fcimb.2021.768182 Wang, S., Zhub, F and Kakuda, Y. 2018. Sacha inchi (Plukenetia volubilis L.): nutritional composition, biological activity, and uses. Food Chem. 265, 316–328; doi: 10.1016/j.foodchem.2018.05.055 Wilairatana, P., Mala, W., Milanez, G.D.J., Masangkay, F.R., Kotepui, K.U. and Kotepui, M. 2022. Increased interleukin-6 levels associated with malaria infection and disease severity: a systematic review and meta-analysis. Sci. Rep. 12(2022), 5982; doi: 10.1038/s41598-022-09848-9 World Health Organization (WHO). 2022. World malaria report 2022. Geneva, Switzerland: World Health Organization. Available via https://www.who.int/teams/global-malaria-programme (Accessed 2 October 2023). Wuttisin, N., Nararatwanchai, T. and Sarikaputi A. 2020. Total phenolic, flavonoid, flavonol contents and antioxidant activity of Inca peanut (Plukenetia volubilis L.) leaves extracts. Food Res. 5, 216–224; doi:10.26656/fr.2017.5(1).346 | ||
| How to Cite this Article |
| Pubmed Style Firdaus RS, Fadilah NF, Suwanti LT, Arwati H, Puspitasari H. Sacha inchi (Plukenetia volubilis) seed oil alleviates Plasmodium berghei infection in mice by reducing proinflammatory cytokine levels and inhibiting parasite growth. Open Vet. J.. 2025; 15(4): 1599-1606. doi:10.5455/OVJ.2025.v15.i4.11 Web Style Firdaus RS, Fadilah NF, Suwanti LT, Arwati H, Puspitasari H. Sacha inchi (Plukenetia volubilis) seed oil alleviates Plasmodium berghei infection in mice by reducing proinflammatory cytokine levels and inhibiting parasite growth. https://www.openveterinaryjournal.com/?mno=229630 [Access: January 25, 2026]. doi:10.5455/OVJ.2025.v15.i4.11 AMA (American Medical Association) Style Firdaus RS, Fadilah NF, Suwanti LT, Arwati H, Puspitasari H. Sacha inchi (Plukenetia volubilis) seed oil alleviates Plasmodium berghei infection in mice by reducing proinflammatory cytokine levels and inhibiting parasite growth. Open Vet. J.. 2025; 15(4): 1599-1606. doi:10.5455/OVJ.2025.v15.i4.11 Vancouver/ICMJE Style Firdaus RS, Fadilah NF, Suwanti LT, Arwati H, Puspitasari H. Sacha inchi (Plukenetia volubilis) seed oil alleviates Plasmodium berghei infection in mice by reducing proinflammatory cytokine levels and inhibiting parasite growth. Open Vet. J.. (2025), [cited January 25, 2026]; 15(4): 1599-1606. doi:10.5455/OVJ.2025.v15.i4.11 Harvard Style Firdaus, R. S., Fadilah, . N. F., Suwanti, . L. T., Arwati, . H. & Puspitasari, . H. (2025) Sacha inchi (Plukenetia volubilis) seed oil alleviates Plasmodium berghei infection in mice by reducing proinflammatory cytokine levels and inhibiting parasite growth. Open Vet. J., 15 (4), 1599-1606. doi:10.5455/OVJ.2025.v15.i4.11 Turabian Style Firdaus, Rizky Setia, Nadiah Farah Fadilah, Lucia Tri Suwanti, Heny Arwati, and Heni Puspitasari. 2025. Sacha inchi (Plukenetia volubilis) seed oil alleviates Plasmodium berghei infection in mice by reducing proinflammatory cytokine levels and inhibiting parasite growth. Open Veterinary Journal, 15 (4), 1599-1606. doi:10.5455/OVJ.2025.v15.i4.11 Chicago Style Firdaus, Rizky Setia, Nadiah Farah Fadilah, Lucia Tri Suwanti, Heny Arwati, and Heni Puspitasari. "Sacha inchi (Plukenetia volubilis) seed oil alleviates Plasmodium berghei infection in mice by reducing proinflammatory cytokine levels and inhibiting parasite growth." Open Veterinary Journal 15 (2025), 1599-1606. doi:10.5455/OVJ.2025.v15.i4.11 MLA (The Modern Language Association) Style Firdaus, Rizky Setia, Nadiah Farah Fadilah, Lucia Tri Suwanti, Heny Arwati, and Heni Puspitasari. "Sacha inchi (Plukenetia volubilis) seed oil alleviates Plasmodium berghei infection in mice by reducing proinflammatory cytokine levels and inhibiting parasite growth." Open Veterinary Journal 15.4 (2025), 1599-1606. Print. doi:10.5455/OVJ.2025.v15.i4.11 APA (American Psychological Association) Style Firdaus, R. S., Fadilah, . N. F., Suwanti, . L. T., Arwati, . H. & Puspitasari, . H. (2025) Sacha inchi (Plukenetia volubilis) seed oil alleviates Plasmodium berghei infection in mice by reducing proinflammatory cytokine levels and inhibiting parasite growth. Open Veterinary Journal, 15 (4), 1599-1606. doi:10.5455/OVJ.2025.v15.i4.11 |